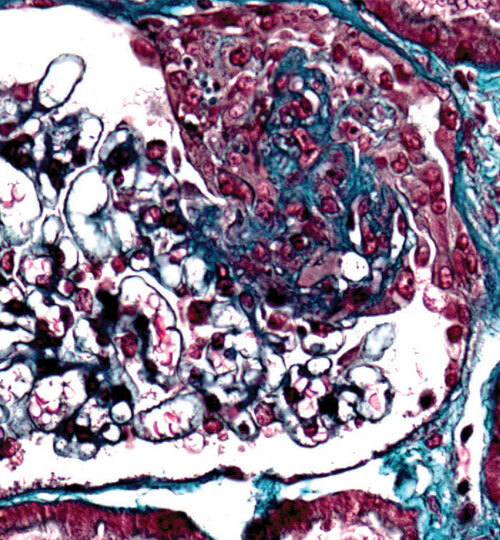

Les vascularites associées aux anticorps anticytoplasme des polynucléaires neutrophiles (ANCA) sont un groupe hétérogène de maladies inflammatoires touchant les vaisseaux de petit calibre. Les données épidémiologiques mettent en lumière l’influence de facteurs environnementaux et génétiques. Les progrès diagnostiques et thérapeutiques sont majeurs, améliorant le pronostic tout en réduisant la toxicité des traitements.
À lire ici :
Guillevin L. Particularités des vascularites associées aux ANCA. Rev Prat 2025 ;75(6) ;612 - 7.
Pacoureau L, Beydon M, Terrier B, et al. Épidémiologie et facteurs de risque des vascularites associées aux ANCA. Rev Prat 2025 ;75(6) ;618 - 25.
Puéchal X. Évolutions récentes dans le traitement des vascularites associées aux ANCA. Rev Prat 2025 ;75(6) ;626 - 30.
Karras A. Vers des thérapies plus ciblées dans le traitement des vascularites à ANCA. Rev Prat 2025 ;75(6) ;631 - 4.
Terrier B. Vascularites associées aux ANCA : les 10 messages clés. Rev Prat 2025 ;75(6) ;635.